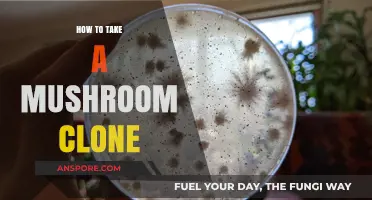
Mastering Mushroom Cloning: A Step-by-Step Guide to Perfect Clones

Taking care of oyster mushrooms is a rewarding process that requires attention to detail and a suitable environment. These fungi thrive in cool, humid conditions, typically between 55°F to 75°F (13°C to 24°C), with humidity levels around 70-80%. Start by using a substrate like straw, sawdust, or coffee grounds, which should be pasteurized to eliminate competing organisms. Inoculate the substrate with oyster mushroom spawn, ensuring even distribution, and place it in a well-ventilated container or grow bag. Maintain consistent moisture by misting the mushrooms daily and avoid direct sunlight, as they prefer indirect light. Harvest when the caps are fully expanded but before the edges curl upward, as this ensures optimal flavor and texture. Proper care and monitoring will yield a bountiful harvest of these delicious and versatile mushrooms.
Explore related products
What You'll Learn
- Optimal Growing Conditions: Maintain humidity (60-70%), temp (65-75°F), and indirect light for healthy growth
- Substrate Preparation: Use straw, sawdust, or coffee grounds, pasteurized to provide nutrient-rich base for mushrooms
- Watering Techniques: Mist daily, keep substrate moist but not soggy to prevent mold and promote fruiting
- Harvesting Tips: Pick mushrooms when caps flatten, twist gently to avoid damaging mycelium
- Pest and Disease Control: Monitor for mites, flies, and mold; use neem oil or biological controls if needed

Optimal Growing Conditions: Maintain humidity (60-70%), temp (65-75°F), and indirect light for healthy growth
To ensure the healthy growth of oyster mushrooms, maintaining optimal environmental conditions is crucial. Humidity levels should be kept between 60% and 70%, as this range mimics the damp environments where these mushrooms naturally thrive. Oyster mushrooms are highly sensitive to dryness, so investing in a hygrometer to monitor humidity is essential. If the air becomes too dry, use a humidifier or mist the growing area lightly with water. Conversely, if humidity exceeds 70%, ensure proper ventilation to prevent mold and other contaminants from affecting the crop.
Temperature plays a pivotal role in the growth of oyster mushrooms, with the ideal range being between 65°F and 75°F (18°C to 24°C). Temperatures outside this range can slow growth or even halt it entirely. Use a thermometer to monitor the growing area, and avoid placing the mushrooms near drafts, heaters, or air conditioners that could cause temperature fluctuations. If the environment is too cold, consider using a heating pad or grow light to gently warm the area, but be cautious not to overheat the mushrooms.
Indirect light is another critical factor for oyster mushroom cultivation. While these mushrooms do not require direct sunlight, they still need some light to trigger the fruiting process. Place the growing container in a well-lit room with natural, indirect light, or use artificial lighting with a timer set to provide 12 hours of light daily. Avoid direct sunlight, as it can dry out the mushrooms and damage their delicate structures. The light should be bright enough to illuminate the room but not intense enough to create heat.
Maintaining these conditions consistently is key to successful oyster mushroom cultivation. Humidity, temperature, and light must be monitored daily, especially during the fruiting stage when mushrooms are most vulnerable. Regularly inspect the growing substrate for signs of dryness or excess moisture, and adjust the environment accordingly. For example, if the substrate feels dry, lightly mist it with water, ensuring not to oversaturate it. Similarly, if condensation builds up inside the growing container, improve ventilation to reduce excess moisture.
Finally, creating a stable microclimate is essential for optimal growth. Consider using a grow tent or a DIY setup with a clear plastic dome to enclose the mushrooms, helping to retain humidity and regulate temperature. Ensure the enclosure has small vents for air exchange while preventing rapid humidity loss. By meticulously controlling humidity, temperature, and light, you can create an ideal environment for oyster mushrooms to flourish, resulting in a bountiful and healthy harvest.
Mushrooms and Asparagus: Unveiling Their Purine Content and Health Impact
You may want to see also

Substrate Preparation: Use straw, sawdust, or coffee grounds, pasteurized to provide nutrient-rich base for mushrooms
Substrate preparation is a critical step in cultivating oyster mushrooms, as it provides the nutrient-rich base necessary for their growth. The choice of substrate—whether straw, sawdust, or coffee grounds—plays a significant role in determining the success of your mushroom crop. Each material offers unique benefits, but all must be properly prepared to ensure optimal conditions for mushroom colonization. Pasteurization is a key process in substrate preparation, as it eliminates competing microorganisms while retaining the nutrients essential for oyster mushrooms.
When using straw as a substrate, begin by selecting dry, clean wheat or rice straw. Chop the straw into 2- to 4-inch pieces to increase the surface area available for mushroom mycelium to grow. Next, pasteurize the straw by soaking it in hot water (170–180°F or 77–82°C) for 1–2 hours. This process kills unwanted bacteria and fungi while preserving the straw’s structure. After pasteurization, drain the straw thoroughly and allow it to cool to room temperature before inoculating it with mushroom spawn. Proper moisture content is crucial, so ensure the straw is damp but not waterlogged.
Sawdust is another popular substrate, especially for growing oyster mushrooms in bags or containers. Use hardwood sawdust, such as oak or beech, as it provides the right balance of nutrients. Pasteurize the sawdust by hydrating it with hot water and then steaming it at 160–180°F (71–82°C) for 1–2 hours. Alternatively, you can pasteurize it by soaking in hot water and then draining and cooling it. Mix the pasteurized sawdust with supplementary nutrients like wheat bran or gypsum to enhance its nutritional value before inoculating with spawn. The sawdust should be moist but well-drained to prevent waterlogging.
Coffee grounds are an eco-friendly substrate option, ideal for small-scale or urban mushroom cultivation. Collect used coffee grounds and mix them with a small amount of straw or sawdust to improve aeration and structure. Pasteurize the mixture by soaking it in hot water (170–180°F or 77–82°C) for 1–2 hours, then drain and cool it. Coffee grounds are naturally rich in nitrogen, which oyster mushrooms thrive on, but they should be used in moderation to avoid excessive moisture retention. A 50:50 mix of coffee grounds and straw or sawdust often yields the best results.
Regardless of the substrate chosen, pasteurization is essential to create a clean and nutrient-rich environment for oyster mushrooms. After pasteurizing, allow the substrate to cool to avoid damaging the mushroom spawn during inoculation. Properly prepared substrate ensures that the mycelium can colonize efficiently, leading to a healthy and abundant mushroom harvest. Always maintain the right moisture levels and avoid contamination by working in a clean environment. With careful substrate preparation, you’ll provide the ideal foundation for your oyster mushrooms to flourish.
Trehouse Mushrooms: Do They Work?
You may want to see also

Watering Techniques: Mist daily, keep substrate moist but not soggy to prevent mold and promote fruiting
Watering is a critical aspect of caring for oyster mushrooms, as it directly influences their growth, fruiting, and overall health. The key principle is to maintain a balance: the substrate must be consistently moist but never waterlogged. Mist daily using a fine spray bottle to create a humid environment that mimics the mushrooms' natural habitat. This light misting ensures the surface remains damp without saturating the substrate. Focus on the walls and ceiling of the growing container, as well as the mushroom caps and stems, to provide adequate moisture without overwatering.
Keeping the substrate moist but not soggy is essential to prevent mold growth, which can outcompete the mushrooms for nutrients. Mold thrives in overly wet conditions, so avoid pouring water directly onto the substrate or allowing standing water to accumulate. Instead, monitor the moisture level by gently pressing your finger into the substrate—it should feel like a wrung-out sponge, slightly damp but not wet. If the substrate feels dry, increase misting frequency, but always err on the side of caution to avoid overwatering.
Daily misting serves a dual purpose: it hydrates the mushrooms and maintains the humidity levels necessary for fruiting. Oyster mushrooms require high humidity (around 80-90%) to develop properly. By misting regularly, you create a microclimate that encourages pinhead formation and healthy fruiting bodies. However, ensure proper ventilation to prevent excess moisture from stagnating, as this can lead to mold or bacterial issues.
To further regulate moisture, consider using a humidity tent or covering the growing container with a clear plastic bag, leaving small openings for air exchange. This setup helps retain humidity while allowing carbon dioxide to escape, which is crucial for mushroom growth. Check the substrate and mushrooms daily, adjusting misting frequency based on environmental conditions—warmer or drier climates may require more frequent watering.
Finally, observe the mushrooms' response to your watering techniques. If the caps begin to dry out or the substrate feels too dry, increase misting. Conversely, if mold appears or the substrate feels soggy, reduce watering and improve ventilation. Consistency and attention to detail in watering will create an optimal environment for oyster mushrooms to thrive, resulting in a bountiful harvest.
Adjusting Your Orbit: Tips for the Mushroom Bubbler
You may want to see also
Explore related products

Harvesting Tips: Pick mushrooms when caps flatten, twist gently to avoid damaging mycelium
Harvesting oyster mushrooms at the right time is crucial for both the quality of the mushrooms and the health of the mycelium. The ideal moment to pick them is when the caps begin to flatten out. This stage indicates that the mushrooms are mature but not overripe, ensuring the best flavor and texture. Younger mushrooms with tightly curled caps are still growing and should be left to develop further. Similarly, mushrooms with fully flattened or delaminated caps are past their prime and may have a softer texture and less desirable taste. Monitoring the caps daily is essential, as oyster mushrooms can mature quickly, especially in optimal growing conditions.
When harvesting, the technique you use is just as important as the timing. To avoid damaging the mycelium—the network of fungal threads that produce the mushrooms—always twist the mushrooms gently at the base of the stem. Pulling or yanking can harm the mycelium, reducing future yields. Hold the mushroom firmly but delicately, and apply a smooth, twisting motion to detach it from the substrate. This method ensures that the mycelium remains intact and can continue to produce more flushes of mushrooms. If the mushroom doesn’t come off easily, it may not be ready, so leave it for another day.
After harvesting, it’s important to handle the mushrooms carefully to maintain their quality. Place them in a basket or tray, avoiding stacking or overcrowding, which can cause bruising. Oyster mushrooms are delicate, and rough handling can damage their gills and caps. If you’re growing mushrooms in a bag or container, take care not to disturb the substrate or expose the mycelium to excessive light or contaminants during the harvesting process. Keeping the growing environment clean and undisturbed helps ensure the longevity of your mushroom crop.
For those growing oyster mushrooms at home, understanding the harvesting process is key to maximizing yields. After the first flush, the mycelium will often produce additional batches of mushrooms. By harvesting correctly—picking at the right time and using the proper technique—you encourage the mycelium to continue fruiting. Be patient and allow the next flush to develop fully before harvesting again. This cycle can repeat several times, depending on the health of the mycelium and the growing conditions. Proper harvesting practices are an investment in the sustainability of your mushroom cultivation efforts.
Lastly, always inspect the harvested mushrooms for any signs of contamination or pests before storing or consuming them. Oyster mushrooms are resilient, but they can still be affected by mold or insects if the growing environment is not maintained properly. After harvesting, clean your tools and the growing area to prevent the spread of contaminants. By following these harvesting tips—picking when caps flatten and twisting gently to protect the mycelium—you’ll enjoy a bountiful and healthy oyster mushroom harvest while ensuring the continued productivity of your mycelium.
Matar Mushroom: A Delicious Combination
You may want to see also

Pest and Disease Control: Monitor for mites, flies, and mold; use neem oil or biological controls if needed
Pest and disease control is a critical aspect of successfully growing oyster mushrooms, as these fungi are susceptible to various pests and pathogens that can quickly compromise your crop. Regular monitoring is the first line of defense; inspect your growing area daily for signs of mites, flies, and mold. Mites are tiny pests that can cause stippling and discoloration on mushroom caps, while flies, particularly sciarid flies, lay eggs that hatch into larvae feeding on the mushroom substrate. Mold, often appearing as fuzzy growth, competes with mushrooms for nutrients and can spread rapidly under humid conditions. Early detection allows for prompt intervention, minimizing damage and ensuring a healthier harvest.
To manage pests like mites and flies, consider using neem oil, a natural and effective solution. Neem oil works as both an insecticide and fungicide, disrupting the life cycle of pests and inhibiting mold growth. Dilute neem oil according to the manufacturer’s instructions and spray it directly onto affected areas or as a preventive measure. Apply it during the cooler parts of the day to avoid stressing the mushrooms. For persistent infestations, repeat the application every 3–5 days until the issue is resolved. Neem oil is safe for organic cultivation and leaves no harmful residues, making it an excellent choice for mushroom growers.
Biological controls offer another eco-friendly approach to pest management. Introduce beneficial organisms like predatory mites, which feed on pest mites, or nematodes that target fly larvae. These natural predators can establish a balanced ecosystem within your growing environment, reducing the need for chemical interventions. Additionally, parasitic wasps can be used to control fly populations by laying eggs inside the larvae, effectively eliminating them. When using biological controls, ensure the environmental conditions (temperature, humidity) are suitable for the beneficial organisms to thrive.
Preventing mold is equally important, as it can quickly spread and ruin your mushroom crop. Maintain proper ventilation to reduce excess humidity, which mold thrives in. If mold is detected, remove the affected substrate or mushrooms immediately to prevent spores from spreading. Applying neem oil or introducing mold-suppressing bacteria, such as *Bacillus subtilis*, can also help control mold growth. Regularly sanitize your growing tools and containers to avoid introducing pathogens to the growing environment.
Finally, maintaining a clean and controlled growing environment is key to minimizing pest and disease issues. Avoid overwatering, as excessive moisture attracts pests and promotes mold. Ensure your substrate is properly pasteurized or sterilized before inoculation to eliminate potential pathogens. By combining vigilant monitoring, natural remedies like neem oil, and biological controls, you can effectively protect your oyster mushrooms from pests and diseases, ensuring a thriving and productive harvest.
Mastering Mushroom Prep: A Step-by-Step Guide to Perfectly Cutting Mushrooms
You may want to see also
Frequently asked questions
Oyster mushrooms thrive in a cool, humid environment with temperatures between 55°F and 75°F (13°C and 24°C). They require high humidity (around 80-90%) and good air circulation to prevent mold and promote healthy growth.
Oyster mushrooms need consistent moisture but not soggy conditions. Mist the growing substrate lightly 1-2 times daily to maintain humidity. Avoid overwatering, as excess moisture can lead to mold or rot.
Yes, oyster mushrooms can be grown indoors using kits or prepared substrates. Ensure they are placed in a well-ventilated area with indirect light, and maintain proper humidity and temperature for successful growth.
Harvest oyster mushrooms by gently twisting or cutting the stems at the base when the caps are still slightly curled. Avoid pulling or damaging the substrate, as healthy mycelium can produce multiple flushes of mushrooms.